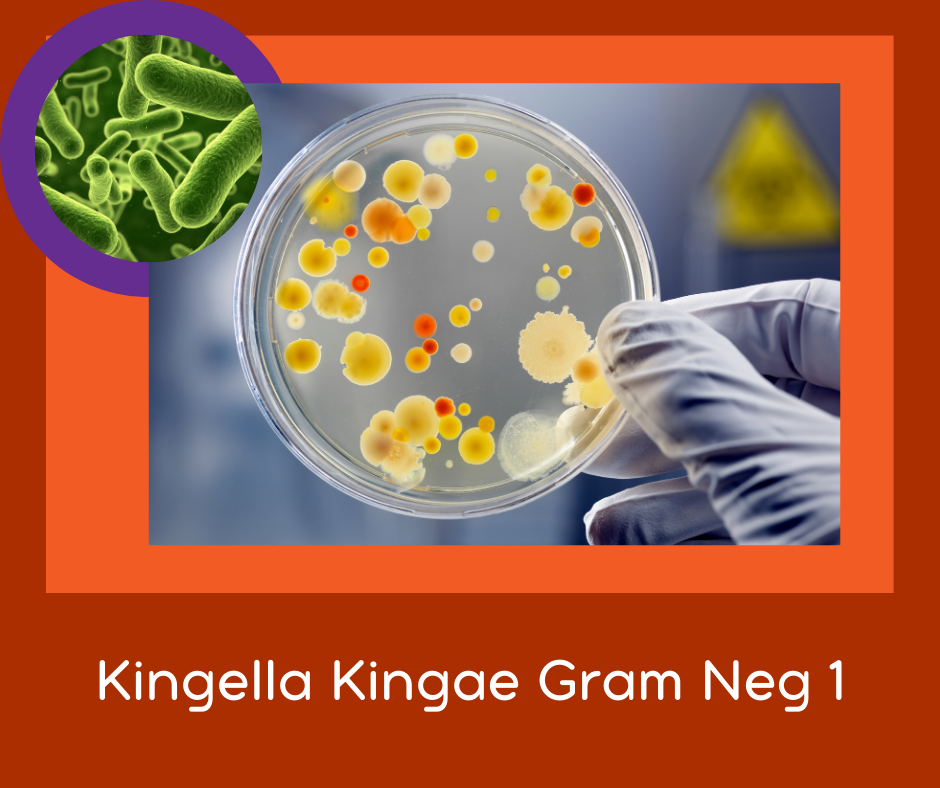

FSR's for Bacterial Infections: Kingella Kingae
FSR's are sound files that, when played on your body, influence the vibration of your body. The result of this is that your system can have a positive change in response to the sound.
This is the Resonance Treatment #1 for Kingella Kingae
Kingella, which belong to the family Neisseriaceae, are short, nonmotile, gram-negative coccobacilli that occur in pairs or short chains. The organisms are slow-growing and fastidious. Kingella are recovered from the human oropharynx and are a rare cause of human disease.
Among Kingella species, Kingella kingae is the most frequent human pathogen; these organisms frequently colonize the mucous membranes of the oropharynx. Children aged 6 months to 4 years have the highest rates of colonization and invasive disease from this pathogen. K. kingae is transmitted from child to child through close personal contact (eg, at day care centers). Infection has a seasonal distribution, with more cases in fall and winter.
I have found the Resonance signature of Kingella in joints to be extremely painful - and the symptoms mimic Rheumatoid Arthritis. This FSR eliminates the pain when diagnosis is accurate.
Place where you need it - most common place is over lungs, but obviously if it is in your joint - place it over your joint.
Official Name: Kingella Kingae

